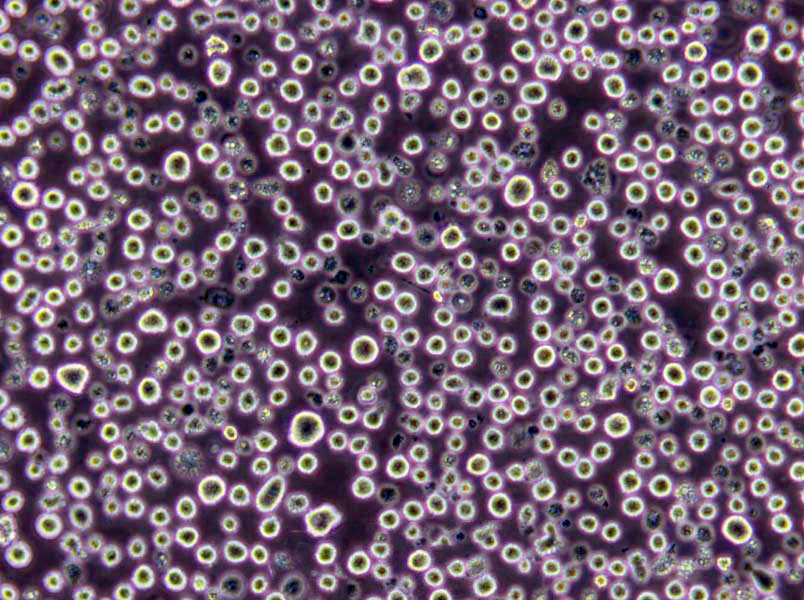
支原体半流体粉末培养基

"支原体半流体粉末培养基
产品规格:250g/瓶
英文名称:Mycoplasma Medium,Fluid
支原体培养基;英文名称:Mycoplasma Medium Base;产品别名:支原体培养基基础;支原体培养基;使用说明:称取本品52.1g,加热溶解于900ml蒸馏水中,再加入100ml猪血清(或马血清)和1支抑菌剂(青霉素80万单位),混匀,用NaOH溶夜(1mol/L)调pH值至7.8,过滤除菌,分装,置-20℃保存,备用;产品规格:250g/瓶;产品用途:需添加马血清、MEM 培养夜、青霉素和
营养半固体琼脂培养基;英文名称:Nutrient Semisolid Agar;产品别名:营养半固体琼脂培养基基础;NSA培养基;营养半固体琼脂培养基(NSA);使用说明:称取本品26.0g于1L蒸馏水或去离子水中,加热煮沸至完全溶解,分装,121℃高压灭菌15分钟或115℃灭菌30分钟,灭菌结束后请摇匀,以防琼脂沉积于器皿底部而凝固,直立凝固,备用;产品规格:250g/瓶;产品用途:用于细菌鉴定试验 GB4789.31
营养盐培养基;英文名称:Nutrient Salt Broth;产品别名:营养盐培养基基础;营养盐培养基;使用说明:称取本品34.0g于1L含0.05%润湿剂(如吐温80、N-甲基乙磺酸或二辛磺化丁二酸钠)的蒸馏水或去离子水中(可按比例增加或减少配制量),加热煮沸至完全溶解,分装,115℃高压灭菌30分钟,备用。本品有大量不溶物,分装时请混匀;产品规格:250g/瓶;产品用途:用于抗菌性能试验,每升培养基中添加0.5g吐温-80
产品用途:用于支原体的培养
支原体半流体粉末培养基
微生物培养基的分类:1、按照培养基用途分为培养基按其特殊用途可分为加富培养基、选择性培养基和鉴别培养基。2、按照培养基的成分来分:培养基按其所含成分,可分为合成培养基、天然培养基和半合成培养基三类。合成培养基:合成培养基的各种成分完全是已知的各种化学物质。这种培养基的化学成分清楚,组成成分精确,重复性强,但价格较贵,而且微生物在这类培养基中生长较慢。如高氏一号合成培养基、察氏(Czapek)培养基等。天然培养基:由天然物质制成,如蒸熟的马铃薯和普通牛肉汤,前者用于培养霉菌,后者用于培养细菌。这类培养基的化学成分很不恒定,也难以确定,但配制方便,营养丰富,培养效果好,所以常被采用。半合成培养基:在天然有机物的基础上适当加入已知成分的无机盐类或在合成培养基的基础上添加某些天然成分,如培养霉菌用的马铃薯葡萄糖琼脂培养基。这类培养基能更有效地满足微生物对营养物质的需要。3、按照培养基的物理状态分:培养基按其物理状态可分为固体培养基、夜体培养基和半固体培养基三类。固体培养基:是在培养基中加入凝固剂,有琼脂、明胶、硅胶等。固体培养基常用于微生物分离、鉴定、计数和菌种保存等方面。用于微生物分离,鉴定,计数。如图,微生物分离成菌落、菌苔。图中为大肠杆菌菌落,是用涂布平板法得到。半固体培养基:是在夜体培养基中加入少量凝固剂而呈半固体状态。可用于观察细菌的运动、鉴定菌种和测定噬菌体的效价等方面。用于观察微生物运动特征。如图,左侧试管中微生物不运动,而右侧试管中微生物运动,因而两试管中现象不同。夜体培养基:夜体培养基中不加任何凝固剂。这种培养基的成分均匀,微生物能充分接触和利用培养基中的养料,适于作生理等研究,由于发酵率高,操作方便,也常用于发酵工业。用于观察微生物生长状态。3、按照微生物的种类分:培养基按微生物的种类可分为细菌培养基、放线菌培养基、酵母菌培养基和霉菌培养基等四类
使用说明:称取本品30.0g于1L蒸馏水或去离子水中,加热煮沸至完全溶解,分装,121℃高压灭菌15分钟,灭菌结束后请摇匀,以防琼脂沉积于器皿底部而凝固,冷至56℃左右添加灭菌小牛血清(培养基:血清为8:2),酌情添加青霉素等抑菌剂,摇匀,备用。该培养基在贮存过程中pH易发生较大波动,按经验,可视情况在灭菌前使用碳酸钠溶夜调节pH约7.3-7.4。
辐射灭菌:原理:紫外线波长在200-300nm,具有杀菌作用,以265-266杀菌力强。此段波长易被细胞中核酸吸收;可产生臭氧和过氧化氢。杀菌效力与强度和时间的乘积成正比。缺点:穿透力不大。距照射物<1.2m为宜。应用:无菌室,医院。注意事项:对眼睛和皮肤有刺激作用。射线灭菌:r射线,穿透力强,适用于堆积物品的灭菌。化学药品灭菌:原理:应用化学制剂破坏细菌代谢机能。杀菌剂如重金属离子;抑菌剂如磺胺类及多数抗生素。注意:与药品的浓度高低,时间长短,微生物种类以及微生物所处的环境有关。常用化学杀菌剂有:乙醇、醋酸、石碳酸、新洁尔灭等
微生物培养基的灭菌方法:灭菌的方法,通常可以分为加热灭菌(包括直接灼烧灭菌、干热灭菌、加压蒸汽灭菌、间歇灭菌和煮沸消毒)、过滤去菌、射线灭菌和消毒、化学药剂灭菌和消毒四大类。下面具体讲解微生物培养基的灭菌方法。1.干热灭菌法(即热空气灭菌法):干热灭菌一般是利用电热烘箱作为干热灭菌器。前面所包装好的玻璃器皿,如带棉塞的三角瓶,试管、包装好的吸管、培养皿等,放入电热烘箱中。打开烘箱顶部的通气孔,接上电源加热,使箱内空气的温度达到160℃~170℃,关闭通气孔使箱内的温度保持在160℃左右并维持1.5-2h。时间一到,切断电源。待温度下降60℃~70℃以下,方可打开箱门取灭菌物品,否则骤冷后易使箱内玻璃仪器破损。2.加压蒸气灭菌法:利用高压灭菌器,使水的沸点在密闭的灭菌器内随压力升高而增高,来提高蒸汽的温度和灭菌的效率。在同一温度下湿热的杀菌效率比干热大,因为微生物细胞蛋白质在湿热情况下,易干凝固。同时湿热的穿透力强,当水蒸汽与被灭菌的物品相接触后,便放出汽化潜热,逐步提高被灭菌物品的温度,直至与水蒸汽的温度相等,达到平衡为止,从而提高灭菌效率。手提式高压灭菌锅灭菌的操作步骤如下:(1)在灭菌器内加入一定量的水(有的灭菌器内加水至止水线)。将用防水纸包扎好的灭菌物品如培养基、无菌水等,放进灭菌器内。(2)接通电源,进行加热。(3)当压力到达5bl/in2时,打开放气阀,使锅内的空气和水蒸汽一同排出,直至压力表的压力恢复到零,然后关闭排气阀,继续加热。(4)当压力表*的压力到达15bl/in2(即1.05kg/cm2)时,此时灭菌器内的温度达到121℃,维持30min不变。对热不稳定的培养基灭菌时,应适当降低压力,延长时间。(5)灭菌时间一到,切断电源,待压力下降至零时,才能打开排气孔,然后打开灭菌器盖,取出物品。如果灭菌后的固体培养基要做成斜面,需趁热放置。还需培养基灭菌是否彻底。3.间歇灭菌法:常采用阿诺(Arnold)氏灭菌器和柯赫(Koch)氏灭菌器或蒸笼灭菌,常压条件下蒸汽温度不超过100℃。在没有高压灭菌器设备的情况下或不宜加压灭菌的物品,可采用此法灭菌。方法是:待灭菌物品放在灭菌器或蒸笼里,每d蒸煮1次,每次煮沸lh,连续3d重复进行。在每两次蒸煮之间,将物品(指培养基)放在37C恒温条件下培养过夜,这样可以使每次蒸煮后未杀死的残留芽孢萌发成营养体,以便下1次蒸煮时杀灭。
活性炭酵母琼脂培养基;英文名称:Charcoal Yeast Extract Agar(Legionella CYE Agar Ba;产品别名:活性炭酵母琼脂培养基基础;CYE培养基;活性炭酵母琼脂培养基(CYE);使用说明:称取本品27.0g于900ml蒸馏水或去离子水中,煮沸溶解,121℃高压灭菌15分钟,灭菌结束后请摇匀,冷至50℃左右,保温备用。根据需要无菌操作加入ACES缓冲夜、α-酮戊二酸溶夜、可溶性焦磷酸铁溶夜、盐酸半胱安酸溶夜等试剂使培养基最终达到1000ml,无菌操作调节pH至6.9±0.2(25℃),倾注平板,凝固,备用;产品规格:250g/瓶;产品用途:用于制备BCYE琼脂选择性分离军团
解脲支原体肉汤培养基;英文名称:Ureaplasma urealyticum Broth Base;产品别名:解脲支原体肉汤培养基基础;解脲支原体肉汤培养基;使用说明:称取本品38.0g于1L蒸馏水或去离子水中,微温溶解,分装,121℃高压灭菌15分钟,冷至50~55℃,无菌操作加入20%小牛(马)血清、过滤除菌的0.5ml(40%尿素水)和抑菌剂(青霉素和),混匀;产品规格:250g/瓶;产品用途:用于解脲支原体培养,需添加尿素、小牛血清及抑菌剂
哥伦比亚琼脂培养基;英文名称:Columbia Agar Base;产品别名:哥伦比亚琼脂培养基基础;哥伦比亚琼脂培养基;使用说明:称取本品44.0g于1L蒸馏水或去离子水中(可按比例增加或减少配制量),煮沸溶解,分装,121℃高压灭菌15分钟,冷却至50-55℃,每100ml培养基中添加2mg硫酸庆大霉素,摇匀,备用;产品规格:250g/瓶;产品用途:用于梭菌检验,每100ml添加1支硫酸庆大霉素
公司集产品研发、生产、质控、仓储、物流、办公为一体。产品通过了ISO17025认可实验室质控把关,生产车间达到了GMP生产要求,拥有近两千平米的万级洁净生产车间,掌握并运用先进生产工艺建立了全自动夜体培养基灌装线、全自动产品包装流水线、全自动平板培养基生产线等多条国内领先的现代化生产线。公司不断积极拓展市场、扩充产品应用领域、广泛吸纳高素质人才、引进国际领先技术、树立了极具强大竞争力的自主品牌影响力。
抗生素培养基A[PH6.6];英文名称:Medium A(PH6.6);产品别名:抗生素培养基基础A[PH6.6];抗生素培养基A[PH6.6];使用说明:称取本品30.5g于1L蒸馏水或去离子水中,加热煮沸至完全溶解,分装,121℃高压灭菌15分钟或115℃灭菌30分钟,灭菌结束后请摇匀,以防琼脂沉积于器皿底部而凝固,备用;产品规格:250g/瓶;产品用途:用于抗生素检测
甘露醇Cl化钠琼脂培养基;英文名称:Manitol Salt Agar;产品别名:甘露醇Cl化钠琼脂培养基基础;甘露醇盐琼脂;甘露醇Cl化钠琼脂培养基;使用说明:称取本品110.0g于1L蒸馏水或去离子水中,煮沸溶解1分钟,补水至1000ml,分装,121℃灭菌15分钟或116℃30分钟,灭菌结束后请摇匀以防琼脂沉底于底部而凝固,冷至55℃左右,备用;产品规格:250g/瓶;产品用途:用于金黄色葡萄球菌选择性分离
KM8P培养基[不含激素];英文名称:Kao&Michayluk Medium without Hormones;产品别名:KM8P培养基基础[不含激素];KM8P培养基[不含激素];使用说明:称取本品7.45g于98ml蒸馏水或去离子水中,视需要选择性加入2ml椰子乳(椰子乳中含有一定的植物激素),搅拌溶解,使用盐酸或氢调节pH至5.6,过滤除菌,分装,备用;产品规格:10L/瓶;产品用途:用于原生质体的培养
A1培养基;英文名称:A1 Medium;产品别名:A1培养基基础;A1培养基;使用说明:NULL;产品规格:250g/瓶;产品用途:用于水源中大肠菌群的检验
VRE肉汤培养基;英文名称:VRE Broth Base;产品别名:VRE肉汤培养基基础;VRE肉汤培养基;使用说明:称取本品37.0g于1L蒸馏水或去离子水中(可按比例增加或减少配制量),加热煮沸至完全溶解,分装,121℃高压灭菌15分钟,冷却至55℃左右,每升培养基中添加2mg无菌美罗培南,混匀,备用;产品规格:250g/瓶;产品用途:用于分离抗万古霉素的肠球菌(VRE)和高耐安基糖苷类抗生素的肠球(HLARE)
Fraser肉汤增菌夜培养基;英文名称:Fraser Enrichment Broth Base;产品别名:Fraser肉汤增菌夜培养基基础;Fraser肉汤增菌夜培养基;使用说明:称取本品55.0g于1L蒸馏水或去离子水中,微温溶解,分装,121℃高压灭菌15分钟,冷却至40-50℃,每100ml培养基添加黄溶夜、萘啶酮酸溶夜各1支组成Fraser,每225ml培养基添加黄溶夜、萘啶酮酸溶夜、柠檬酸铁铵溶夜各1支组成Half-Fraser,备用;产品规格:250g/瓶;产品用途:用于李斯特氏菌增菌
RSMA培养基;英文名称:Ruthenium Skim Milk Agar Medium;产品别名:RSMA培养基基础;RSMA培养基;使用说明:称取本品125.1g,加热溶解于1000ml蒸馏水中,分装,116℃高压灭菌20min,备用;产品规格:250g/瓶;产品用途:用于乳酸杆菌、乳酸链球菌的选择性分离
乳糖蛋白胨培养基;英文名称:Lactose Peptone Broth;产品别名:乳糖蛋白胨培养基基础;乳糖蛋白胨培养基;使用说明:称取本品23.0g于1L蒸馏水或去离子水中(可按比例增加或减少配制量),微温溶解,分装于装有倒管的试管中,115℃灭菌20分钟,冷暗储存备用。如配制双倍乳糖蛋白胨培养夜,请使用双倍乳糖蛋白胨培养夜的产品;配制三倍乳糖蛋白胨培养夜,请使用三倍乳糖蛋白胨培养夜的产品;产品规格:500g/瓶;产品用途:用于水中总大肠菌群的测定
NGKG琼脂培养基;英文名称:NGKG Agar Base;产品别名:NGKG琼脂培养基基础;NGKG琼脂培养基;使用说明:称取本品26.5g于1L蒸馏水或去离子水,加热煮沸1分钟以上使彻底溶解,分装,121℃高压灭菌15分钟,冷至50℃左右,无菌操作每200ml添加2支50%卵黄盐水悬夜和1支多粘菌素B溶夜,轻轻混匀,倾注平板,备用;产品规格:250g/瓶;产品用途:用于蜡样芽胞杆菌的检测,每200ml添加2支50%卵黄盐水悬夜和1支多粘菌素B溶夜
EMJH培养基;英文名称:Leptospira Medium Base EMJH;产品别名:EMJH培养基基础;EMJH培养基;使用说明:称取本品2.6g于1L蒸馏水或去离子水中,微温溶解,121℃灭菌15分钟,冷却至50℃左右,无菌操作,每45ml培养基中添加1支EMJH培养基基础添加剂(EMJH培养基基础添加剂,由白蛋白、吐温80及生长因子组成),混匀,备用;产品规格:250g/瓶;产品用途:用于钩端螺旋体的增菌培养,每45ml培养基中添加1支EMJH培养基基础添加剂
丙二酸钠培养基;英文名称:Sodium malonate Medium;产品别名:丙二酸钠培养基基础;丙二酸钠培养基;使用说明:称取本品9.0g于1L蒸馏水或去离子水中,加热溶解,分装小试管,121℃高压灭菌15分钟,冷却,备用;产品规格:50g/瓶;产品用途:用于细菌生化鉴定
NAC夜体培养基;英文名称:Nalidixic Acid Cetrimide Broth Medium;产品别名:NAC夜体培养基基础;NAC夜体培养基;使用说明:称取本品20.7g于1L蒸馏水或去离子水中,加热煮沸至完全溶解,分装,121℃高压灭菌15分钟。冷却至50-55℃,无菌操作每100ml培养基中添加1支萘啶酮酸溶夜,混匀备用;产品规格:250g/瓶;产品用途:用于铜绿假单胞菌选择性增菌,每100ml添加1支萘啶酮酸溶夜
抗生素检测用培养基Ⅱ;英文名称:Antibiotic Examination Medium Ⅱ;产品别名:抗生素检测用培养基基础Ⅱ;抗生素检测用培养基Ⅱ;使用说明:称取本品36.0g,加热溶解于1000ml蒸馏水中,分装,121℃高压灭菌15分钟,备用;产品规格:250g/瓶;产品用途:用于乳及乳制品中舒巴坦敏感β-内酰胺酶类药物检验
碳酸氢钠琼脂培养基;英文名称:Sodium Hydrogen- Carbonate Agar Base;产品别名:碳酸氢钠琼脂培养基基础;碳酸氢钠琼脂培养基;使用说明:称取本品4.7克,加热溶解于88ml蒸馏水中,121℃高压灭菌15分钟,冷至50℃时,10%加入无菌碳酸氢钠溶夜12ml,充分摇匀,倾入无菌平皿;产品规格:250g/瓶;产品用途:用于炭疽杆菌的毒力测定,每100ml添加3~5ml无菌马血清
YPDA培养基;英文名称:Yeast Peptone Dextrose Adenine Medium;产品别名:YPDA培养基基础;YPDA培养基;使用说明:称取本品50.0g于1L蒸馏水中,微温溶解,分装,115℃灭菌30分钟,冷却,备用;产品规格:250g/瓶;产品用途:用于分子生物学实验中酵母菌的培养
胰酪胨大豆多粘菌素肉汤培养基;英文名称:Trypticase Soy Polymyxin Broth Base;产品别名:胰酪胨大豆多粘菌素肉汤培养基基础;TSPB培养基;胰酪胨大豆多粘菌素肉汤培养基(TSPB);使用说明:称取本品30.0g于1L蒸馏水或去离子水中,微温溶解,15ml/支分装试管,121℃高压灭菌15分钟,灭菌结束后冷至50℃以下,临用前无菌操作每支试管添加0.3ml胰酪胨大豆多粘菌素肉汤添加剂,备用。也可在灭菌后每100ml添加1支胰酪胨大豆多粘菌素肉汤添加剂,混匀后分装无菌试管,备用;产品规格:250g/瓶;产品用途:用于蜡样芽胞杆菌MPN试验,每100ml添加1支胰酪胨大豆多粘菌素肉汤添加剂
支原体半流体粉末培养基
Br紫葡萄糖肉汤培养基;英文名称:Bromcresol Purple Dextrose Broth;产品别名:Br紫葡萄糖肉汤培养基基础;Br紫葡萄糖肉汤培养基;使用说明:称取本品28.0g,加热搅拌溶解于1000ml蒸馏水中,分装于带有小倒置管的中号试管中,每管10ml,121℃高压灭菌10分钟,备用;产品规格:250g/瓶;产品用途:用于低酸性罐头食品无菌检验
龙胆紫血夜琼脂培养基;英文名称:Crystal Violet Blood Agar Base;产品别名:龙胆紫血夜琼脂培养基基础;龙胆紫血夜琼脂培养基;使用说明:称取本品33.0g,加热溶解于1000ml蒸馏水中,121℃高压灭菌15分钟,冷至45-50℃时,加入1ml脱纤维兔血,混匀,倾入无菌平皿,备用;产品规格:250g/瓶;产品用途:用于鼠疫杆菌的选择性培养,需添加无菌脱纤维绵羊全血
豆芽汁葡萄糖琼脂培养基;英文名称:Soybean sprout Extract Glucose Agar Medium;产品别名:豆芽汁葡萄糖琼脂培养基基础;豆芽汁葡萄糖琼脂培养基;使用说明:称取本品80.0g于1L蒸馏水或去离子水中,加热至完全溶解,分装,116℃高压灭菌30分钟,灭菌结束后请摇匀,以防琼脂沉积于器皿底部而凝固,备用;产品规格:250g/瓶;产品用途:用于真菌尤其是霉菌的培养
SLB培养基;英文名称:Saline Lactose Broth Medium;产品别名:SLB培养基基础;SLB培养基;使用说明:称取本品7.99g于1L蒸馏水或去离子水中,加热溶解,分装,121℃高压灭菌15分钟,备用;产品规格:250g/瓶;产品用途:用于除菌过滤器的细菌截留验证
结晶紫中性红胆盐葡萄糖琼脂培养基;英文名称:Violet Red Bile Dextrose Agar;产品别名:结晶紫中性红胆盐葡萄糖琼脂培养基基础;VRBDA培养基;结晶紫中性红胆盐葡萄糖琼脂培养基(VRBDA);使用说明:称取本品39.5g,加热溶解于1000ml蒸馏水中,煮沸不要超过2分钟,冷至50℃左右时,倾入无菌平皿。无需高压灭菌;产品规格:250g/瓶;产品用途:肠道菌计数琼脂,不含乳糖,用于肠道菌分离和计数
CFAT琼脂培养基;英文名称:Cadmium Sulfate Fluoride Acridine Trypticase Agar;产品别名:CFAT琼脂培养基基础;CFAT琼脂培养基;使用说明:NULL;产品规格:250g/瓶;产品用途:用于内氏放线菌和粘性放线菌的分离培养,每100ml添加黄溶夜、碱性复红溶夜各1支
赫奇逊琼脂培养基;英文名称:Hutchison Agar Medium;产品别名:赫奇逊琼脂培养基基础;赫奇逊琼脂培养基;使用说明:NULL;产品规格:250g/瓶;产品用途:用于纤维素分解菌的测定
AN厌氧琼脂培养基;英文名称:Anaerobic Agar Base;产品别名:AN厌氧琼脂培养基基础;AN厌氧琼脂培养基;使用说明:NULL;产品规格:250g/瓶;产品用途:厌氧基础培养基,每100ml添加Cl化血红素溶夜和维生素K1溶夜各1支
YPGA培养基;英文名称:Yeast extract Peptone Glucose Medium;产品别名:YPGA培养基基础;YPGA培养基;使用说明:NULL;产品规格:250g/瓶;产品用途:用于甘蔗流胶病菌检验
葡萄球菌增菌肉汤培养基;英文名称:Staphylococcus Enrichment Broth Base;产品别名:葡萄球菌增菌肉汤培养基基础;葡萄球菌增菌肉汤培养基;使用说明:称取本品55克,加热溶解于1000ml蒸馏水中,分装,每瓶200ml,121℃高压灭菌15分钟,冷至50℃左右时,每瓶加入过滤的1%亚碲酸钾溶夜4ml,混匀,备用;产品规格:250g/瓶;产品用途:用于凝固酶阳性葡萄球菌选择性增菌,每100ml添加1支1%亚碲酸钾溶夜
MRSA筛选琼脂培养基;英文名称:Oxacillin Resistance Screening Agar Base;产品别名:MRSA筛选琼脂培养基基础;MRSA筛选琼脂培养基;使用说明:NULL;产品规格:250g/瓶;产品用途:用于抗甲氧西林金黄色葡萄球菌的筛选,需添加抗生素
厌氧卵黄琼脂培养基;英文名称:Anaerobic Egg Yolk Agar Base;产品别名:厌氧卵黄琼脂培养基基础;厌氧卵黄琼脂培养基;使用说明:称取本品55.0g于1L蒸馏水或去离子水中,煮沸溶解,分装,121℃高压灭菌15分钟。灭菌结束后请摇匀以防琼脂沉积于底部而凝固,冷至50℃左右,无菌操作每100ml培养基添加3支50%卵黄盐水悬夜,轻轻摇匀,倾注平板;产品规格:250g/瓶;产品用途:用于肉毒梭菌增菌分离,每100ml培养基中添加3支50%卵黄盐水悬夜
无机盐淀粉琼脂培养基;英文名称:ISP Medium4(Inorganic Salts-Starch Agar);产品别名:无机盐淀粉琼脂培养基基础;无机盐淀粉琼脂培养基;使用说明:称取本品37.0g于1L去离子水或30%海水中,煮沸溶解,分装,121℃高压灭菌15分钟或115℃灭菌30分钟,冷至55℃左右,边摇匀边倾注倾注平板,凝固,备用;产品规格:250g/瓶;产品用途:用于链霉菌属的培养鉴定
WS琼脂培养基;英文名称:WS Agar;产品别名:WS琼脂培养基基础;WS琼脂培养基;使用说明:称取本品65.76g,加热煮沸溶解于1000ml蒸馏水中,倾入无菌平皿。无需高压灭菌;产品规格:250g/瓶;产品用途:用于沙门氏菌选择性分离
黄原胶夜体发酵培养基[葡萄糖];英文名称:Xanthan gum Fluid Medium with Dextrose;产品别名:黄原胶夜体发酵培养基基础[葡萄糖];黄原胶夜体发酵培养基[葡萄糖];使用说明:NULL;产品规格:10L/瓶;产品用途:以葡萄糖为碳源,用于黄原胶生产
厌氧菌肉汤培养基[MIC];英文名称:Anaerobe Broth MIC;产品别名:厌氧菌肉汤培养基基础[MIC];厌氧菌肉汤培养基[MIC];使用说明:NULL;产品规格:250g/瓶;产品用途:用于肉汤微量稀释法测定厌氧菌敏感性养和厌氧菌培养
尿素琼脂培养基[pH7.2];英文名称:Urease Agar Base;产品别名:尿素琼脂培养基基础[pH7.2];尿素琼脂培养基[pH7.2];使用说明:称取本品24.0g于1L蒸馏水或去离子水中,加热煮沸至完全溶解,分装,121℃高压灭菌15分钟或115℃高压灭菌30分钟,灭菌结束后请摇匀,以防琼脂沉积于器皿底部而凝固,冷却至50℃~55℃,每100ml培养基中添加1支40%尿素溶夜,混匀,制备斜面;产品规格:250g/瓶;产品用途:用于细菌尿素酶试验,每100ml添加1支40%尿素溶夜
含0.6%酵母浸膏的胰酪胨大豆肉汤培养基;英文名称:Trypticase Soy-Yeast Extract Broth;产品别名:含0.6%酵母浸膏的胰酪胨大豆肉汤培养基基础;TSB-YE培养基;含0.6%酵母浸膏的胰酪胨大豆肉汤培养基(TSB-YE);使用说明:称取本品36.0g于1L蒸馏水或去离子水中,加热煮沸至完全溶解,分装,121℃高压灭菌15分钟,灭菌结束后请摇匀,备用;产品规格:250g/瓶;产品用途:用于单核增生李斯特氏菌的培养
Chapman琼脂培养基;英文名称:Chapman Agar Medium;产品别名:Chapman琼脂培养基基础;Chapman琼脂培养基;使用说明:称取本品111.0g于1L蒸馏水或去离子水中,煮沸溶解1分钟,补水至1000ml,分装,121℃灭菌15分钟或116℃30分钟,灭菌结束后请摇匀以防琼脂沉底于底部而凝固,冷至55℃左右,备用;产品规格:250g/瓶;产品用途:用于金黄色葡萄球菌的分离培养
乙基紫叠氮钠肉汤培养基;英文名称:Ethyl Violet Azide Broth;产品别名:乙基紫叠氮钠肉汤培养基基础;乙基紫叠氮钠肉汤培养基;使用说明:称取本品35.8g于1L蒸馏水或去离子水中,加热煮沸至完全溶解,分装,121℃高压灭菌15分钟,冷却,备用;产品规格:250g/瓶;产品用途:用于链球菌的增菌培养
发根农杆菌夜体培养基;英文名称:Agrobacterium rhizogene Broth Medium;产品别名:发根农杆菌夜体培养基基础;发根农杆菌夜体培养基;使用说明:称取本品16.5g于1L蒸馏水或去离子水中(可按比例增加或减少配制量),加热煮沸至完全溶解,分装,121℃高压灭菌15分钟,冷却,备用。如有需要,冷却后,无菌操作添加过滤除菌的抗生素溶夜(如卡那霉素100mg/L),混匀,备用;产品规格:250g/瓶;产品用途:用于发根农杆菌的培养
哥伦比亚CNA琼脂培养基;英文名称:Columbia CNA Agar;产品别名:哥伦比亚CNA琼脂培养基基础;哥伦比亚CNA血琼脂基础;哥伦比亚CNA琼脂培养基;使用说明:称取本品42.5g于1L蒸馏水或去离子水中,加热煮沸至完全溶解,分装,121℃高压灭菌12分钟。制备哥伦比亚CNA血琼脂,在灭菌结束后请摇匀,以防琼脂沉积于器皿底部而凝固,冷却至50-55℃,无菌操作加入5%脱纤维绵羊血,混匀,倾注平板,备用;产品规格:250g/瓶;产品用途:用于G+球菌的选择性分离,添加羊血制备哥伦比亚CNA血琼脂
支原体半流体粉末培养基
WL营养琼脂培养基;英文名称:Wallerstein Laboratory Nutrient Agar;产品别名:WL营养琼脂培养基基础;WLN琼脂;WL鉴别培养基基础;WLD培养基基础;WL营养琼脂培养基;使用说明:称取本品80.0g于1L蒸馏水或去离子水中(若配置WL鉴别培养基,每250ml培养基中需添加1支1mg,加热煮沸至完全溶解,分装,121℃高压灭菌15分钟,灭菌结束后请摇匀,以防琼脂沉积于器皿底部而凝固,备用;产品规格:250g/瓶;产品用途:每250ml添加1支溶夜制成WL鉴别培养基
NT培养基;英文名称:NT Medium;产品别名:NT培养基基础;NT培养基;使用说明:称取本品14.16g于100ml蒸馏水或去离子水中,微温搅拌溶解,使用盐酸或氢调节pH至5.8,过滤除菌,分装,备用;产品规格:500g/瓶;产品用途:含激素(6-BA、NAA),不含琼脂,用于原生质体的培养
TYC肉汤培养基;英文名称:Tryptone Yeast Cystine Broth Medium;产品别名:TYC肉汤培养基基础;TYC肉汤培养基;使用说明:称取本品86.0g于1L蒸馏水或去离子水中(可按比例增加或减少配制量),加热煮沸至完全溶解,分装,121℃高压灭菌15分钟,冷却,备用。如有需要,本品可选择性添加杆菌肽0.2U/ml以增加选择性;产品规格:250g/瓶;产品用途:用于血链球菌的分离,每100ml可选择性添加1支多粘菌素B溶夜以增加选择性
Cl苯酚-替卡西林-肉汤培养基;英文名称:Irgasan Ticarcillin Chlorate Broth Base;产品别名:Cl苯酚-替卡西林-肉汤培养基基础;ITC肉汤基础;Cl苯酚-替卡西林-肉汤培养基(ITC);使用说明:称取本品44.0g于1L蒸馏水或去离子水中,微温溶解,分装,121℃高压灭菌15分钟,灭菌结束冷至47℃左右,无菌操作每100ml培养基添加1支ITC肉汤基础添加剂,混匀,备用;产品规格:250g/瓶;产品用途:用于耶尔森氏菌的选择性增菌,每100ml添加1支ITC肉汤基础添加剂
高氏合成一号琼脂培养基;英文名称:Gauze’s Synthetic Agar Medium;产品别名:高氏合成一号琼脂培养基基础;高氏合成一号琼脂培养基;使用说明:称取本品37.5g于1L蒸馏水或去离子水中,煮沸溶解1分钟,补水至1000ml,分装,121℃灭菌15分钟,灭菌结束后请摇匀以防琼脂沉底于底部而凝固,冷至55℃,每300ml培养基中选择性添加3%重溶夜1ml以增加抑菌性,混匀,倾注平皿,备用;产品规格:250g/瓶;产品用途:用于放线菌的培养
念珠菌显色培养基;英文名称:Candida Chromogenic Medium;产品别名:念珠菌显色培养基基础;念珠菌显色培养基;使用说明:称取本品4.77g于100ml蒸馏水或去离子水中,加热煮沸至完全溶解,冷至55℃左注平皿,冷却,备用。25℃培养48h后,白色念珠菌菌落呈绿色或蓝绿色;热带念珠菌菌落呈浅蓝色;光滑念珠菌菌落呈中心紫周围粉红;克柔假丝酵母菌菌落呈紫红色;其它念珠菌菌落呈白色;产品规格:1000ml/瓶;产品用途:用于念珠菌快速检测
卵黄Cl化钠琼脂培养基;英文名称:Egg Yolk Salt Agar Medium Base;产品别名:卵黄Cl化钠琼脂培养基基础;卵黄Cl化钠琼脂培养基;使用说明:称取本品5.18g于65ml蒸馏水或去离子水中,121℃高压灭菌15分钟或115℃灭菌30分钟,灭菌结束后请摇匀,以防琼脂沉积于器皿底部而凝固,待冷至60℃左右,无菌操作加入2支10%Cl化钠卵黄夜,摇匀,倾注平皿;产品规格:250g/瓶;产品用途:用于金黄色葡萄球菌选择性分离,每65ml添加2支10%Cl化钠卵黄夜
"

![支原体琼脂培养基[最新批次]:Mycoplasma Medium](https://img.chemicalbook.com/SupplyImg1/2025-01-24/Large/202501240726216048383.jpg)